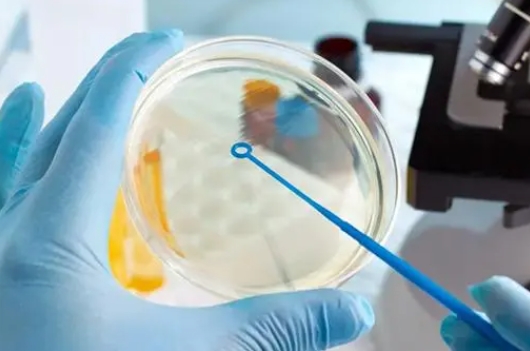

在北京进行试管婴儿手术,需要满足以下条件:适应症条件:输卵管不通:如输卵管梗阻,导致精子与卵子无法在输卵管内受精。排卵障碍:如反复不排卵或促排卵失败。严重的子宫

郑州三代试管好的私立医院收费项目具体包括哪些呢?下面将为您一一解析。一、基础检查与评估费用在进行三代试管婴儿治疗前,夫妻双方需要进行一系列的基础检查与评估,以了
原标题:支原体和衣原体感染对试管婴儿有影响吗?许多不孕症患者应该熟悉术语“衣原体”。现代社会中的现代人生活节奏很快。许多人不能养成良好的生活习惯和饮食习惯,而且

成都正规试管助孕中心一览,为您详细介绍试管助孕作为一项先进的生殖辅助技术,为众多不孕不育的夫妻带来了希望。在成都,有许多正规的试管助孕中心,它们以专业的技术、优
原标题:试管催促结果不幸发现雌激素低?由于多种原因,包括排卵障碍在内,女性会出现不孕症。如果女性不能正常排出成熟的卵子,就会发生不孕症。为了解决这个问题,我现在
泰国三代试管婴儿的费用因医院、医生、方案、技术等因素而异,一般在10-20万人民币之间。其中比较主要的费用包括:前期检查费用、促排卵药物费用、取卵取精费用、胚胎

随着科技的进步和医疗技术的发展,试管婴儿技术已经成为了许多不孕不育家庭的希望。在日本试管婴儿技术同样发展迅速,吸引了众多海外患者。在日本做试管,理解每一步的重要

原标题:有一个龙和一个婴儿有多难!看看做试管的成本。试管婴儿多胎的成本与单胎和多胎的成本相同。国内外试管婴儿医院众多,技术参差不齐,成本差异很大。试管婴儿费用主
一、什么是黄体血肿及其影响黄体血肿是育龄妇女中的一种常见疾病,轻微情况下可以自行消退,但严重时可能导致不孕。它通常是单侧的,直径大约为40㎜,有时甚至可达到10

什么是试管婴儿孩子的步骤?完成特性,带了体检报告,带着兴奋的心来到泰国做一个试管婴儿帮助怀孕,目的是要有一个孩子,那么泰国后如何实现一个孩子?这个过程是什么?这






